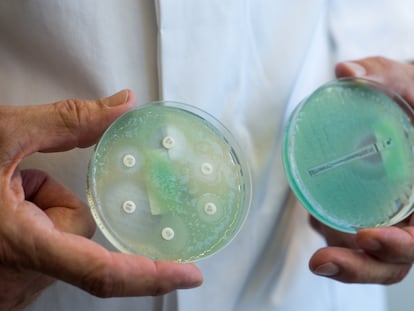

La superbacteria capaz de resistir a antibióticos
El ‘Staphylococcus aureus’ resistente a la meticilina, que causa 120.000 muertes al año, adopta un modo alternativo de división celular para asegurar su supervivencia
Un puñado de microbios ha puesto contra las cuerdas la salud mundial. Son las superbacterias, consideradas por la Organización Mundial de la Salud (OMS) una de las 10 principales amenazas para la salud pública y causantes de 1,27 millones de muertes al año. La OMS tiene, en concreto, en el punto de mira a una quincena de microorganismos considerados “altamente peligrosos” por su resistencia al arsenal de antibióticos disponibles y su capacidad para propagarse o transmitir las resistencias a otras bacterias. Son enemigos declarados, por ejemplo, las bacterias gramnegativas resistentes, la Salmonella, la Shigella, la Pseudomonas aeruginosao el Staphylococcus aureus resistente a meticilina, entre otros. Sobre este último, una investigación publicada el jueves en la revista Science ha ahondado en sus mecanismos de escape a los antimicrobianos y ha descubierto que, para ser altamente resistentes, estos microbios adoptan una doble defensa.
Solo el Staphylococcus aureus resistente a la meticilina (SARM) causa unas 120.000 muertes al año en el mundo. Es “una amenaza mundial grave”, explica Simon Foster, investigador de la Universidad de Sheffield (Reino Unido) y autor del estudio que revela un nuevo mecanismo de defensa de esta bacteria. La meticilina era el antibiótico que se usaba tradicionalmente contra este microbio, pero debido a la aparición del SARM y a la toxicidad del propio medicamento, cuenta Foster, se dejó de utilizar. El problema es que la meticilina pertenece a una familia más amplia de antibióticos, los betalactámicos, y el SARM se ha vuelto resistente a casi todos ellos. “El SARM a veces se puede tratar con otros antibióticos, como linezolida o tetraciclina. Sin embargo, para infecciones graves, como la bacteriemia o la endocarditis, se debe utilizar daptomicina o vancomicina. El problema es que se han desarrollado resistencias contra cada uno de ellos”, justifica el experto.Más información
Hace tiempo que la comunidad científica descubrió que el SARM tenía una peculiaridad: había adquirido un gen que codifica un componente llamado MecA, que ayuda a formar las paredes celulares de la bacteria para que crezca y se divida. Esta particularidad genómica la hace resistente, pero los investigadores sabían que solo esa característica no era suficiente para ser altamente resistente. “También se sabía que hay otros pequeños cambios que ocurren en las bacterias y que permiten un gran salto en el nivel de resistencia”, agrega Foster en una respuesta por correo electrónico. Los científicos pensaban que estos pequeños cambios genéticos, llamados “potenciadores” en el argot científico, permitían que MecA funcionara mejor.
Sin embargo, expone el investigador de la Universidad de Sheffield, su nuevo hallazgo ha dado una vuelta de tuerca a los planteamientos iniciales y ha revelado que esos potenciadores “no están relacionados con la actividad de MecA, sino que forman parte de otro mecanismo necesario para la resistencia de alto nivel”. Concretamente, los autores descubrieron que el SARM adopta un modo alternativo de división celular en presencia de antimicrobianos para asegurar su supervivencia. “Al utilizar el mecanismo recién descubierto, las bacterias se dividen de una forma diferente que no requiere una actividad clave que normalmente se necesita para que se dividan y se multipliquen”, señala el investigador.
Estos dos mecanismos de defensa son sinérgicos: “Ambos son necesarios para que la resistencia a la meticilina sea de alto nivel. Es necesario que MecA sea resistente a un nivel bajo, aproximadamente 10 veces más que una cepa sensible, y que la potenciación sea resistente a un nivel alto, aproximadamente 1.000 veces más que una cepa sensible. La potenciación por sí sola no las hace resistentes”, cuenta Foster.
Según los autores, su descubrimiento abre las puertas a encontrar nuevas estrategias terapéuticas para luchar contra las resistencias a los antibióticos. Foster defiende que el hallazgo de ese nuevo mecanismo de división hasta ahora desconocido es importante en dos niveles: “En primer lugar, se ha demostrado que estas bacterias tienen la capacidad de dividirse de una forma desconocida hasta ahora, lo que arroja luz sobre los mecanismos que sustentan la vida de este organismo. En segundo lugar, demuestra que el desarrollo de la resistencia es más complejo de lo que habíamos imaginado anteriormente y utiliza la vía recién descubierta, lo que tiene ramificaciones importantes para el desarrollo de nuevos tratamientos para controlar el SARM”. El científico asegura que ya hay compuestos a los que esta bacteria resistente es vulnerable, y se podría mapear la actividad en cada uno de sus dos sistemas de defensa para buscar otros nuevos tratamientos.
Un patógeno preocupante
Bruno González-Zorn, director de la Unidad de Resistencias Antimicrobianas de la Universidad Complutense de Madrid y asesor de la Organización Mundial de la Salud (OMS) en este campo, incide en que el SARM es uno de los patógenos “que más mortalidad y más preocupación genera a nivel hospitalario” y cualquier avance en el conocimiento de la biología de las resistencias que genera, como esta investigación, es “importante”: “Se trata de un artículo de biología fundamental donde describe que el SARM adquiere un gen que le confiere una resistencia. Pero uno de cada 10.000 de esos consigue tener una resistencia muy alta y, hasta ahora, no se sabía qué es lo que lo hacía altamente resistente porque ese gen solo era insuficiente. El nuevo hallazgo no tendrá una implicación clínica inmediata, pero sí abre la puerta a diseñar moléculas para inhibir ese alto nivel de resistencia”, reflexiona el microbiólogo, que no ha participado en esta investigación.
En la misma línea se pronuncia María del Mar Tomás, microbióloga del Complexo Hospitalario Universitario de A Coruña y portavoz de la Sociedad Española de Infecciosas y Microbiología Clínica (SEIMC): “Es interesantísimo. Muchas investigaciones se han centrado en los mecanismos de resistencia clásica, los que actúan sobre los antibióticos, pero este estudio mira a los mecanismos de tolerancia y estrés de la bacteria, que pueden influir también en la resistencia”. Tomás señala que la investigación de Foster, en la que ella no ha participado, encuentra “el nexo perfecto” para explicar la alta resistencia del SARM a los antibióticos: “Es un mecanismo que combina la unión del MecA con una mutación en genes potenciadores relacionados con la división celular: la bacteria crece de forma diferente, anómala y desordenada, pero que logra que el antibiótico no actúe”.
La investigación publicada en Science también plantea nuevas incógnitas por resolver, admite Foster. Por ejemplo, si el SARM puede tener otros mecanismos ocultos para sortear a los antibióticos: “Nuestro descubrimiento de este nuevo mecanismo que utiliza una estrategia de división alternativa demuestra lo poco que sabemos. Actualmente, estamos trabajando para dilucidar la base del modo de división alternativa y cómo los potenciadores realmente funcionan para promover la resistencia. Esto nos permite descubrir toda una gama de capacidades celulares que ahora podemos explorar. Siempre hay más por descubrir y comprender”, asume el científico.
Otra cuestión en el aire es si esas mismas vías de defensa se replican en otras bacterias resistentes. Por lo pronto, avanza Foster, los potenciadores están asociados con la resistencia a otros tipos de antibióticos y se han encontrado en otras bacterias. “Estamos trabajando para determinar si existe un hilo conductor común entre las bacterias y si dicho mecanismo es más frecuente de lo que habríamos sugerido anteriormente”, apunta.
Fuente: El Pais
